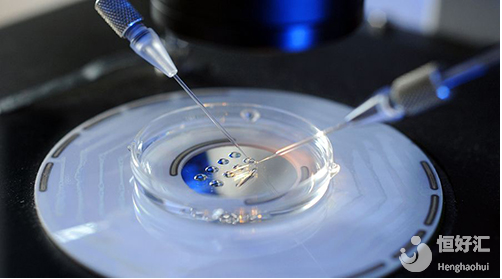
試管嬰兒胚胎冷凍要怎樣進行？

大家應該都清楚的了解,通過試管技術生育孩子是屬于無性生殖,而精子和卵子是在體外受精形成受精卵的,于是就有很多人好奇,精子和卵子在離開人體之后盡然還能有活力,而且還能受精成功,如此神奇的事情使人感到驚訝萬分。

在婦科疾病之中,子宮肌瘤是目前最常見的一種良性腫瘤,不會危及生命,大部分是沒有明顯癥狀的,較為少數表現為陰道出血,腹部有腫脹感以及壓迫癥等等。
試管嬰兒到治療后期,一些患者除了移植一到兩個胚胎之外,可能還會有多余的胚胎,這個時候醫生一般都會建議患者進行冷凍,以便后期再次使用,能夠免去患者再接受取卵環節。

許多人都會疑惑睪丸扭轉是什么?為什么會出現這種情況?睪丸扭轉其實又稱為精索扭轉,這是因為有少部分人在胎兒發育時期,睪丸系膜過長而導致孩子出生后,睪丸和精索活動度增大,則此時就會造成睪丸扭轉,且程度不一。

精索靜脈曲張是什么?名字聽起來好高大上的感覺,精索靜脈曲張(Varicocele,VC)其實是一種血管病變,主要是由精索內蔓狀靜脈叢異常擴張所引起的,可使男性朋友性睪丸功能減退,是男性不育癥常見的原因之一。

李先生和張女士在婚姻的愛河中已經走過15年,雖然生活富足,婚姻幸福,但始終沒有自己的孩子,這對于處在中年時期的夫妻來說,是殘酷的。李先生說他和妻子算是晚婚的,太太比他小6歲,身體一切都很正常,但是他自己去醫院檢查,醫生說他是弱精癥者,李先生始終對太太張女士有愧疚之情,但是太太每次都給李先生安慰,說總會有辦法的。為了要孩子,曾經李先生夫婦在國內做過2次試管嬰兒,但是結果都以失敗告終,唯一慶幸的就是當時張女士還在美國進行了卵子冷凍,當時冷凍了15顆卵子,到現在已經有5年了。